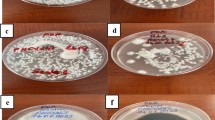

Abstract
Antifungal properties of Boerhavia diffusa L. (Nyctaginaceae) methanolic extract have been investigated against Phytophthora infestans and Phytophthora capsici, causal agents of late blight disease in tomato and pepper, respectively. The minimum inhibitory concentration of B. diffusa extract was 0.25 % for P. infestans and 0.5 % for P. capsici. The extract had fungitoxic effect on P. infestans and completely inhibited its mycelial growth at all tested concentrations (0.25, 0.5, and 1 %). P. capsici mycelial growth was inhibited of 90 % by the 1 % extract after five days of culture. B. diffusa extract, at the concentration of 0.25 % significantly reduced P. infestans disease symptoms also in young tomato plants. The plant extract significantly reduced disease symptoms of P. capsici in young pepper plants at all tested concentrations (0.25, 0.5, and 1 %). The efficacy of B. diffusa extract against P. capsici increased with the increasing extract concentration and decreased over time. The 1 % concentration showed the best efficacy in controlling this oomycete. As its effect was comparable to that of the synthetic fungicide, B. diffusa extract can be considered as a potential environmentally friendly alternative to chemical control of late blight in tomato and pepper.
Similar content being viewed by others
Avoid common mistakes on your manuscript.
Introduction
Phytophthora spp. are oomycete pathogens causing diseases in many crops throughout the world. Some of the most devastating diseases are caused by P. infestans, the causal agent of late blight of potatoes and tomatoes, and P. capsici which can cause serious damage in pepper. Disease management is complex because some strains of P. infestans and P. capsici have become resistant to the most common fungicides (Pomerantz et al. 2015; Pang et al. 2014). In addition, it is difficult to obtain cultivars completely resistant to these pathogens (Crinò 1993). Therefore, it is necessary to find other alternatives of Phytophthora disease management.
Current demand for environmentally friendly disease management has favored research on the plant-protective substances of natural origin (Švecová and Crinò 2013; Rosado-Álvarez et al. 2014; Tamuli et al. 2014). Recently, several substances derived from plants such as Allium sativum, Azadirachta indica (Ngadze 2014), Artemisia absinthium (Rodino et al. 2014), and Ficus tikoua (Wei et al. 2012) have shown antifungal activity against P. infestans. Some compounds of plants such as Allamanda cathartica (Mone et al. 2014), Alstonia rupestris (Zhang et al. 2014), and Magnolia liliflora (Bajpai and Kang 2012) have demonstrated efficacy particularly against P. capsici. However, several authors suggested that some degree of resistance could be developed by Phytophthora spp. also against chemical compounds contained in plant extracts, as observed with synthetic fungicides (Widmer and Laurent 2006). For this reason there is a continuous need of new sources of active compounds efficient against Phytophthora spp.
Boerhavia diffusa L. (Nyctaginaceae) is a promising plant to be investigated for its antifungal properties against Phytophthora spp. In fact, this perennial herb, distributed in the tropical and subtropical regions, is known to contain many active compounds located mainly in its root (Singh 2007). Its ethnobotanical use has a long history (Awasthi and Verma 2006). It has shown diuretic (Madhuri and Kalasker 2013), antimicrobial (Apu et al. 2012), anti-cancer (Saraswati et al. 2013), hepatoprotective (Monali and Ramtej 2014) and antioxidant (Patel et al. 2014) properties.
The bioactive properties of B. diffusa have been attributed to its content of alkaloids, carbohydrates, saponins, pseudotannins, tannins, anthocyanin, steroidal glycosides, glycosides, flavonoids, flavones, coumarin, resins, phenol, xantho-proteins, oil, fats (Bharathi et al. 2014), vitamins and minerals (Khalid et al. 2012). In addition, the antifungal properties of B. diffusa roots have been attributed to 5,7-dihydroxy flavone, an active principle against the human dermatophyte Microsporum gypseum (Agrawal and Srivastava 2008). Although the antifungal and antibacterial properties of B. diffusa against human pathogens have been investigated (Wagh and Vidhale 2010), there is a lack of studies on B. diffusa efficiency against plant pathogens so far (Singh et al. 2011; Lohani et al. 2007). This is the first report of B. diffusa antifungal properties against the phytopathogenic fungi P. infestans and P. capsici on tomato and pepper, respectively.
Materials and methods
Plant material
Crude methanol extract from roots of B. diffusa was obtained by the Soxhlet extraction technique (Harborne 1998). Solvent was evaporated and the resultant crude extract was concentrated to dryness under reduced pressure as described by Bhardwaj et al. (2014). According to Oboh et al. (2007), the obtained solid crude extract was reconstituted with sterile distilled water to prepare a stock solution at the concentration of 80 mg·ml−1. For the experiments the stock solution was further diluted by mixing with V8 medium (for in vitro tests) or adding water (for in vivo tests) to reach the final tested concentrations containing 0.25, 0.5, and 1 % of original crude B. diffusa extract. Tomato cv. Superprecoce di Marmande (N. Sgaravatti & C. S.p. A, Pergine Valdarno - Arezzo, Italy) and pepper cv. Quadrato d’Asti Giallo selection Cubo (Four Sementi – Blumen Group spa, Milano, Italy) were used for in vivo tests.
Pathogens
Isolates of P. infestans and P. capsici, kindly provided by fungal collections of Tuscia (Viterbo, Italy) and Naples (Portici, Italy) Universities, respectively, were re-isolated from infected plant organs. Pure cultures of P. capsici were maintained on V8 medium (V8 juice 200 ml, plant agarose 15 g, CaCO3 2 g, distilled water up to the final volume of 1000 ml); P. infestans was maintained on the V8 medium amended with boiled peas (V8 200 ml, agarose 15 g, CaCO3 0.5 g, 100 g of boiled peas, distilled water up to final volume of 1000 ml). In vitro and in vivo experiments were carried out using 10-day-old cultures of both pathogens.
In vitro antifungal assays
Toxicity tests of plant extract against the fungi were performed with the poisoned plate technique, according to the procedure proposed by Abou-Jawdah et al. (2002). Plant extract, sterilized by filtration through 0.2 μl Millipore filter, was added to V8 substrate after autoclaving, when the temperature of the medium reached 50 °C, and mixed thoroughly. The final volume of the extract in 20 ml of V8 per each Petri dish was adjusted to four different final concentrations (0.25, 0.5, 1, and 2 %). V8 plates unamended with plant extracts served as controls.
Mycelial growth inhibition tests were performed by placing in the center of each plate 3 pieces of 5 mm mycelial agar discs cut from the margin of actively growing fungal colonies. Colony diameter was measured after 5 days of incubation of P. capsici at 27 °C and P. infestans at 21 °C. Mycelial development was observed for 11–13 days. All treatments were replicated 5 times and the whole experiment was repeated 3 times. The percentage of inhibition was calculated comparing treated plates with the control, whose inhibition was established as 0 %. The Minimum Inhibitory Concentration (MIC) was established as the lowest extract concentration that resulted in no visible mycelial growth after 20 h (Osorio et al. 2010).
In vivo antifungal assays
In the growth chamber experiment, two weeks after sowing in a peat substrate, tomato plants at the two-leaf stage were sprayed with a fungal suspension containing 4 × 104 sporangia·ml−1 of P. infestans. Treatments with B. diffusa extract at three different concentrations (0.25, 0.5 and 1 %; 1.3 ml per plant) were carried out one day after inoculation. Inoculated controls treated with a chemical fungicide (Ridomil Gold, 4 g·l−1) or distilled water, an uninoculated control treated with extract at 1 % to exclude phytotoxicity caused by the extract, and an uninoculated control treated with distilled water were established. Each treatment consisted of 30 plants with three replicates. The treatments were repeated weekly for the total of four applications. The plants were kept at the temperature of 19-20 °C and high relative humidity. The experiment was repeated three times. Disease severity was assessed by means of a visual rating according to a 0–3 scale (0 = no symptoms - 3 = plant dead). The evaluation of disease incidence was carried out at 6th, 10th and 17th day after inoculation.
In the growth chamber experiment, a suspension containing 2 × 104 sporangia·ml−1 of P. capsici was applied to the soil and to the collets of pepper plants at four-leaf stage, 30 days after sowing in a peat-sand (2:1) substrate. Treatments with B. diffusa extract at three different concentrations (0.25, 0.5 and 1 %; 6 ml per plant) were carried out immediately after inoculation. Inoculated controls treated with a chemical fungicide (Ridomil Gold, 4 kg·ha−1) or distilled water, an uninoculated control treated with extract at 1 % to exclude phytotoxicity caused by the extract, and an uninoculated control treated with distilled water were established. Each treatment consisted of 30 plants with three replicates. The treatments were repeated weekly for the total of 4 applications. The plants were kept at the temperature of 27 °C and high relative humidity. The experiment was repeated three times. Disease severity was assessed by means of a visual rating according to a 0–5 scale modified from Bosland and Lindsey (1991): 0 = no symptoms, vigorous, healthy (as in uninoculated control), 1 = apparently healthy and vigorous with very small lesions beginning to form on stem, 2 = slight stunting, very small lesions on stem, lower leaves wilted, 3 = small lesions on stem, leaves wilted, plant stunted, 4 = large lesions on stem, stem girdling, whole plant wilted and stunted, 5 = all leaves withered (of brown color), dead plant. Figure 1 displays the indicative grades of visual rating. The evaluation of disease incidence was carried out at 6th, 9th, 12th, and 16th day after inoculation.
Statistical analysis
Data were subjected to one-way analysis of variance (anova) using SPSS 15.0 software. The follow up of anova included Duncan’s multiple range test (P < 0.05) to determine the significant differences between treatments.
Results and discussion
In vitro antifungal assays
After 20 h of incubation, the MIC of B. diffusa extract was assessed as 0.25 % and 0.5 % for P. infestans and P. capsici, respectively. Similar observations were performed at the 5th day of fungal culture when the mycelial growth was clearly visible; P. infestans was inhibited by 100 % at all tested concentrations (Figs. 2 and 3), while P. capsici was inhibited by 90 % at the concentration of 1 % (Figs 4 and 5). The antifungal effect of B. diffusa extract against P. infestans was already evident at its low concentrations. The antifungal effect against P. capsici increased along with increasing concentration, as reported also for the oil of Metasequoia glyptostroboides against P. capsici spore germination (Bajpai et al. 2009). Although the mechanisms of action of B. diffusa against Phytophthora spp. are unknown, some authors have observed the negative impact on fungal morphology by plant extracts, e.g. negative alteration of P. infestans hyphae treated with A. sinaica extract (Baka 2014). Similar effects were not evident in our in vitro tests. In addition, Demirci and Dolar (2006) observed that onion, radish, garden cress, and lentil extracts stimulated mycelial growth of P. capsici, which used these extracts as a source of energy. On the other hand, Widmer and Laurent (2006) observed a greater inhibition of Phytophthora spore germination caused by natural plant extract in comparison with the same compounds contained in the extract but obtained synthetically due to a slight difference in their chemical structure. This indicates the importance of natural provenience of biofungicides.
In vivo antifungal assays
Figure 6 reports the development of disease symptoms of P. infestans on tomato plants. At six days after inoculation, there was no significant difference between the levels of the disease symptoms on plants pre-treated with B. diffusa extract at 0.5 and 1 % and on inoculated control. The percentage of disease in the plants treated with the 0.25 % B. diffusa extract was even higher in comparison with the inoculated control plants and the plants treated with higher doses of the plant extract. Ten and 15 days after inoculation the disease symptoms continued to develop in the plants treated with B. diffusa extract at 0.5 and 1 % but in the plants treated with 0.25 % extract the disease development was suppressed. The level of control of tomato late blight by 0.25 % B. diffusa extract was significantly higher than that over time conferred by the synthetic fungicide. In fact, the fungitoxic effects comparable to that of the synthetic fungicides have already been reported for some plant extracts indicating them as valuable components for integrated disease management of tomato late blight (Goufo et al. 2010).
Percentage of disease in tomato plants after P. infestans inoculation and/or B. diffusa extract treatment. According to Duncan’s multiple range test, different letters indicate significant differences among treatments (P < 0.05). (C) Plants treated with distilled water; (IT 0.25) plants treated with B. diffusa extract (0.25 %) and inoculated with P. infestans; (IT 0.5) plants treated with B. diffusa extract (0.5 %) and inoculated with P. infestans; (IT 1) plants treated with B. diffusa extract (1 %) and inoculated with P. infestans; (I) plants inoculated with P. infestans; (IF) plants treated with synthetic fungicide and inoculated with P. infestans; (T 1) plants treated with B. diffusa extract (1 %)
The in vivo trials confirmed the results of in vitro tests since the efficacy of B. diffusa extract at the lowest concentration tested (0.25 %) resulted effective also in mycelial growth inhibition of P. infestans. However, higher extract concentrations have not been capable of controlling the disease probably due to their phytotoxicity effect, as confirmed by the damages on plants treated only with the 1 % extract. The phytotoxicity symptoms increased over time along with repeated treatments.
At the end of the trial, the level of phytotoxicity of the inoculated plants treated with the 1 % extract was much lower than that of the control plants treated only with the 1 % extract. This suggests that the phytotoxicity symptoms have been mitigated somehow. The simultaneous application of plant extract and the pathogen might have induced some synergistic effect, which triggered the accelerated defense response in tomato plants (Švecová et al. 2013) resulting in milder phytotoxicity symptoms. In fact, the potential of plant extracts to induce defense responses in plants has been reported, e.g. P. infestans in tomato might be controlled by the sugar beet extract which induced resistance to this pathogen by activating pathogenesis related proteins (Baka 2014). However, at the 10th day after inoculation, disease incidence in the plants treated with 1 % extract was even higher than in the inoculated control plants, probably due to the initial weakening of plants by phytotoxicity reaction which aggravated the disease symptoms. The initial worsening of disease symptoms might indicate that there is a certain amount of time needed for manifesting induced disease responses.
In light of the results, the extract concentration of 0.25 % has been identified as the maximum efficient concentration to be applicable at the tested plant developmental stage. Since B. diffusa extract revealed to be a promising natural antifungal agent for the control of late blight in young tomato plants, further trials should be conducted also on adult plants in order to verify the efficacy of the plant extract including its potential phytotoxicity effect at higher concentrations. The leaves of adult tomato plants are supposed to be less susceptible to the application of the B. diffusa extract and also less sensitive to the disease depending on growing conditions. Therefore, in adult plants higher extract concentrations might be employed to confer even higher protection against this disease.
According to Curtis et al. (2004), infection of potato tubers by P. infestans was more effectively reduced by prophylactic treatments with garlic extract than by post infection curative treatments. This option could be considered also for the application of B. diffusa extract. It is supposed that several applications of lower extract doses before disease attack might prevent or reduce the disease development without collateral phytotoxicity effects. Moreover, in adult plants, the application of plant extracts may lead to an increase in fruit yield of tomato in correspondence with the reduction of disease severity, as reported by Baka (2014).
In pepper, B. diffusa extract reduced P. capsici disease symptoms at all tested concentrations compared to the inoculated and untreated control (Fig. 7). Its efficacy increased with the increasing extract concentration and decreased over time. The most efficient concentration of the B. diffusa extract was 1 % as confirmed also by previous in vitro tests. In addition, its antifungal effect was comparable to that of the synthetic fungicide. In general, this means a great advantage for a biofungicide as it has been often found less effective in comparison with commercial synthetic fungicides (Park et al. 2003).
Percentage of disease in tomato plants after P. capsici inoculation and/or B. diffusa extract treatment. According to Duncan’s multiple range test, different letters indicate significant differences among treatments (P < 0.05). (C) Plants treated with distilled water; (T 1) plants treated with B. diffusa extract (1 %); (IF) plants treated with synthetic fungicide and inoculated with P. capsici; (IT 1) plants treated with B. diffusa extract (1 %) and inoculated with P. capsici; (IT 0.5) plants treated with B. diffusa extract (0.5 %) and inoculated with P. capsici; (IT 0.25) plants treated with B. diffusa extract (0.25 %) and inoculated with P. capsici; (I) plants inoculated with P. capsici
Apart from the in vitro tests that showed a direct anti-oomycete effect, the exact mode of action of the B. diffusa extract has not been elucidated yet. However, there is a report on both direct and indirect protection from P. capsici by water extract of compost in pepper: the direct inhibition of P. capsici population in the soil suppressed the disease in the root, and indirect inhibition of foliar infection was conferred through induced systemic resistance (Sang et al. 2010).
No phytotoxicity has been observed in young pepper plants after treatment with B. diffusa extract. This is a promising indication for the employment of B. diffusa extract for P. capsici disease management also in adult pepper plants.
The employment of B. diffusa raw extract comprises several advantages for the sustainable disease management of Phytophthora diseases such as a low cost and simple extraction process in comparison with isolation of single active compounds. Moreover, it was reported that only the mixture of single compounds from the microbicidal fraction of the plant extract of Artemisia ludoviciana has shown similar effect against Phytophthora spp. as the raw extract (Damian Badillo et al. 2010). In addition, plant drugs used in traditional medicine, such as B. diffusa, have low biotoxicity to humans (Park et al. 2003) which is another important benefit of plant extracts’ use in crop disease management.
Conclusions
B. diffusa extract showed significant antifungal activity in controlling P. infestans and P. capsici similarly to synthetic fungicide. Therefore, this plant extract can be considered as an alternative to control these pathogens in young tomato and pepper plants under protected conditions. However, the efficacy of B. diffusa extract should be explored also under field conditions and in adult plants.
References
Abou-Jawdah, Y., Sobh, H., & Salameh, A. (2002). Antimycotic activities of selected plant flora, growing wild in Lebanon, against phytopathogenic fungi. Journal of Agricultural and Food Chemistry, 50(11), 3208–3213.
Agrawal, A., & Srivastava, M. M. (2008). Structural elucidation of bioactive principle of root of Boerhavia diffusa for its antifungal properties. National Academy Science Letters, 31(7–8), 215–219.
Apu, A. S., Liza, M. S., Jamaluddin, A. T. M., Howlader, M. A., Saha, R. K., Rizwan, F., & Nasrin, N. (2012). Phytochemical screening and in vitro bioactivities of the extracts of aerial part of Boerhavia diffusa Linn. Asian Pacific Journal of Tropical Biomedicine, 2(9), 673–678.
Awasthi, L. P., & Verma, H. N. (2006). Boerhaavia diffusa - a wild herb with potent biological and antimicrobial properties. Asian Agri-History, 10(1), 55–68.
Bajpai, V. K., & Kang, S. C. (2012). In vitro and in vivo inhibition of plant pathogenic fungi by essential oil and extracts of Magnolia liliflora desr. Journal of Agricultural Science and Technology, 14(4), 845–856.
Bajpai, V. K., Lee, T. J., & Kang, S. C. (2009). Chemical composition and in vitro control of agricultural plant pathogens by the essential oil and various extracts of Nandina domestica Thunb. Journal of the Science of Food and Agriculture, 89(1), 109–116.
Baka, Z. A. M. (2014). Antifungal activity of extracts from five Egyptian wild medicinal plants against late blight disease of tomato. Archives of Phytopathology and Plant Protection, 47(16), 1988–2002.
Bharathi, K., Thirumurugan, V., Kavitha, M., Muruganandam, G., & Sethuraman, M. (2014). Inter-specific variation studies on the phyto-constituents of Boerhaavia diffusa L. And Cichorium intybus L. Using phytochemical methods. International Journal of Pharmaceutical Sciences Review and Research, 27(1), 283–287.
Bhardwaj, R., Yadav, A., & Sharma, R. (2014). Phytochemicals and antioxidant activity in Boerhavia diffusa. International Journal of Pharmacy and Pharmaceutical Sciences, 6(1), 344–348.
Bosland, P. W., & Lindsey, D. (1991). A seedling screen for Phytophthora root rot of pepper. Capsicum annuum. Plant Dis., 75, 1048–1050.
Crinò, P. (1993). Phytophthora infestans/Patata, pomodoro. In P. Crinò, A. Sonnino, F. Saccardo, M. Buiatti, A. Porta-Puglia, & G. Surico (Eds.), Miglioramento genetico delle piante per resistenza a patogeni e parassiti (pp. 310–335). Bologna, Italia: Edagricole.
Curtis, H., Noll, U., Störmann, J., & Slusarenko, A. J. (2004). Broad-spectrum activity of the volatile phytoanticipin allicin in extracts of garlic (Allium sativum L.) against plant pathogenic bacteria, fungi and oomycetes. Physiological and Molecular Plant Pathology, 65(2), 79–89.
Damian Badillo, L. M., Martinez Muñoz, R. E., Salgado Garciglia, R., & Martinez Pacheco, M. M. (2010). In vitro antioomycete activity of Artemisia ludoviciana extracts against Phytophthora spp. Boletin Latinoamericano y del Caribe de Plantas Medicinales y Aromaticas, 9(2), 136–142.
Demirci, F., & Dolar, F. S. (2006). Effects of some plant materials on Phytophthora blight (Phytophthora capsici Leon.) of pepper. Turkish Journal of Agriculture and Forestry, 30(4), 247–252.
Goufo, P., Fontem, D. A., & Ngnokam, D. (2010). Evaluation of plant extracts for tomato late blight control in Cameroon. New Zealand Journal of Crop and Horticultural Science, 38(3), 171–176.
Harborne, J. B. (1998). Phytochemical methods: a guide to modern techniques of plant analysis (third ed.). London: Chapman & Hall Pub.
Khalid, M., Siddiqui, H. H., & Freed, S. (2012). Pharmacognostical evaluation and qualitative analysis of Boerhaavia diffusa L. Roots. International Journal of Pharma and Bio Sciences, 3(1), P16-P23.
Lohani, S., Jan, A., & Verma, H. N. (2007). In vivo and in vitro resistance induction in tobacco by Boerhaavia diffusa systemic resistance inducing protein and transfer of induced resistance in in vitro tobacco plants. Biotechnology, 6(3), 389–392.
Madhuri, S., Kalasker, V., Rambhimaiah, & Sreekantha (2013). Evaluation of diuretic activity of aqueous extract of Boerhaavia diffusa roots in rats. International Journal of Pharma and Bio Sciences, 4(4), P843-P848.
Monali, P., & Ramtej, V. (2014). Hepatoprotective activity of Boerhavia diffusa extract. International Journal of Pharmaceutical and Clinical Research, 6(3), 233–240.
Mone, M., Saieed, M. A. U., Dastogeer, K. M. G., Ali, M. A., & Meah, M. B. (2014). Plumieride from Allamanda cathartica as an inhibitory compound to plant pathogenic fungi. Archives of Phytopathology and Plant Protection, 47(11), 1311–1326.
Ngadze, E. (2014). In vitro and greenhouse evaluation of botanical extracts for antifungal activity against Phythopthora infestans. Journal of Biopesticides, 7(2), 199–204.
Oboh, I., Akerele, J., & Obasuyi, O. (2007). Antimicrobial activity of the ethanol extract of the aerial parts of Sida acuta Burm Malvaceae. Tropical Journal of Pharmaceutical Research, 6, 809–813.
Osorio, E., Flores, M., Hernández, D., Ventura, J., Rodríguez, R., & Ahuilar, C. N. (2010). Biological efficiency of polyphenolic extracts from pecan nuts shell (Carya Illinoensis), pomegranate husk (Punica granatum) and creosote bush leaves (Larrea tridentata Cov.) against plant pathogenic fungi. Industrial Crops and Products, 31(1), 153–157.
Pang, Z., Shao, J. P., Hu, J., Chen, L., Wang, Z., Qin, Z., & Liu, X. (2014). Competition between pyrimorph-sensitive and pyrimorph-resistant isolates of Phytophthora capsici. Phytopathology, 104(3), 269–274.
Park, H. J., Lee, J. Y., Moon, S. S., & Hwang, B. K. (2003). Isolation and anti-oomycete activity of nyasol from Anemarrhena asphodeloides rhizomes. Phytochemistry, 64(5), 997–1001.
Patel, M., Verma, R., & Srivastav, P. (2014). Antioxidant activity of Boerhavia diffusa extract. International Journal of Pharmacognosy and Phytochemical Research, 6(3), 598–605.
Pomerantz, A., Cohen, Y., Shufan, E., Ben-Naim, Y., Mordechai, S., Salman, A., & Huleihel, M. (2015). Characterization of Phytophthora infestans resistance to mefenoxam using FTIR spectroscopy. Journal of Photochemistry and Photobiology B: Biology, 141, 308–314.
Rodino, S., Cornea, C. P., Butu, A., & Butu, M. (2014). Control of tomato late blight with Artemisia absinthium extracts. Acta Horticulturae, 1041. doi:10.17660/ActaHortic.2014.1041.26.
Rosado-Álvarez, C., Molinero-Ruiz, L., Rodríguez-Arcos, R., & Basallote-Ureba, M. J. (2014). Antifungal activity of asparagus extracts against phytopathogenic Fusarium oxysporum. Scientia Horticulturae, 171, 51–57.
Sang, M. K., Kim, J. G., & Kim, K. D. (2010). Biocontrol activity and induction of systemic resistance in pepper by compost water extracts against Phytophthora capsici. Phytopathology, 100(8), 774–783.
Saraswati, S., Alhaider, A. A., & Agrawal, S. S. (2013). Punarnavine, an alkaloid from Boerhaavia diffusa exhibits anti-angiogenic activity via downregulation of VEGF in vitro and in vivo. Chemico-Biological Interactions, 206(2), 204–213.
Singh, A. (2007). Boerhavia diffusa: An-overexploited plant of medicinal importance in eastern Uttar Pradesh. Current Science 93(4), p. 446.
Singh, S., Awasthi, L. P., & Singh, R. K. (2011). Induction of systemic resistance through antiviral agents of plant origin against papaya ring spot disease (Carica papaya L.). Archives of Phytopathology and Plant Protection, 44(17), 1676–1982.
Švecová, E., & Crinò, P. (2013). Plant-derived biofungicides: overview and perspectives. In M. N. Wheeler & B. R. Johnston (Eds.), Fungicides: classification, role in disease management and toxicity effects (pp. 1–38). New York: Nova Science Publishers.
Švecová, E., Proietti, S., Caruso, C., Colla, G., & Crinò, P. (2013). Antifungal activity of Vitex agnus-castus extract against Pythium ultimum in tomato. Crop Protection, 43, 223–230.
Tamuli, P., Das, J., & Boruah, P. (2014). Antifungal activity of Vitex negundo Linn. against some phytopathogenic fungi. Plant Archives, 14(2), 981–982.
Wagh, S., & Vidhale, N. N. (2010). Antimicrobial efficacy of Boerhaavia diffusa against some human pathogenic bacteria and fungi. Biosciences, Biotechnology Research Asia, 7(1), 267–272.
Wei, S., Wu, W., & Ji, Z. (2012). New antifungal pyranoisoflavone from Ficus tikoua bur. International Journal of Molecular Sciences, 13(6), 7375–7382.
Widmer, T. L., & Laurent, N. (2006). Plant extracts containing caffeic acid and rosmarinic acid inhibit zoospore germination of Phytophthora spp. pathogenic to Theobroma cacao. European Journal of Plant Pathology, 115(4), 377–388.
Zhang, L., Hua, Z., Song, Y., & Feng, C. (2014). Monoterpenoid indole alkaloids from Alstonia rupestris with cytotoxic, antibacterial and antifungal activities. Fitoterapia, 97, 142–147.
Acknowledgments
This work is a part of Eva Švecová’s PhD program in Horticulture at University of Tuscia, Viterbo, in collaboration with ENEA C.R. Casaccia, Rome, Italy.
Author information
Authors and Affiliations
Corresponding author
Rights and permissions
About this article
Cite this article
Švecová, E., Colla, G. & Crinò, P. Antifungal activity of Boerhavia diffusa L. extract against Phytophthora spp. in tomato and pepper. Eur J Plant Pathol 148, 27–34 (2017). https://doi.org/10.1007/s10658-016-1065-9
Accepted:
Published:
Issue Date:
DOI: https://doi.org/10.1007/s10658-016-1065-9